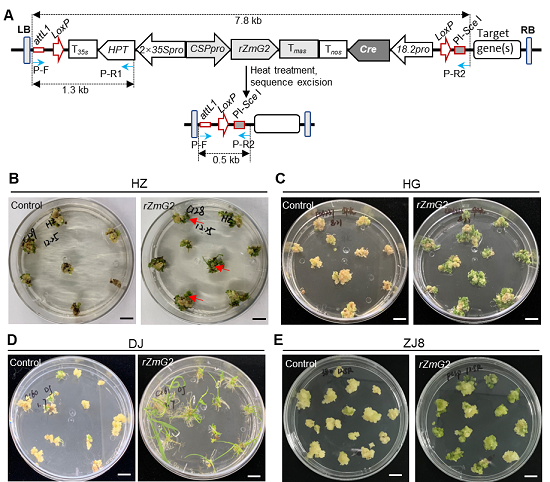

近日,我校华南农业大学生科院、亚热带农业生物资源保护与利用国家重点实验室、岭南现代农业科学与技术广东省实验室刘耀光院士团队,在国际知名学术期刊SCIENCE CHINA Life Sciences(IF2021=10.372,生物学1区)在线发表题为“Overexpression of maize GOLDEN2 in rice and maize calli improves regeneration by activating chloroplast development”的研究论文(论文链接:https://www.sciengine.com/SCLS/doi/10.1007/s11427-022-2149-2)。该研究揭示了在水稻和玉米的愈伤组织中过表达玉米GOLDEN2基因可促进愈伤的分化,从而提高遗传转化效率。

在遗传转化的过程中,愈伤组织或外植体组织再生效率的高低直接影响目的基因转化的成功率。籼稻、玉米一直存在遗传转化难的问题。近年来报道了通过在愈伤组织或外植体过表达一些植物发育调节因子或复合体如WUS/BBM,GRF/GIF,WOX5等可以促进植物体细胞胚的产生或芽的再生,从而提高基因转化效率。GOLDEN2(G2)是GARP转录因子超家族中的一员,其调控叶绿体的发育,还参与生物胁迫、植物衰老、植物激素信号传导等生物学过程。
该研究对玉米G2基因进行水稻密码子优化合成了rZmG2基因,并从水稻中分离鉴定到愈伤特异强启动子CSPpro (callus-specific promoter),构建了CSPpro驱动rZmG2基因且具有热激诱导自删除的双元载体pYLTAC380H-CSPpro::rZmG2。将此载体转化粳稻(DongJing和中嘉8号)、籼稻(华占和华光)以及玉米(B104)。在愈伤分化阶段,转化rZmG2基因的水稻和玉米愈伤组织会提前转绿且绿点变多(如下图1),分化效率提高11.6-48.7%,转化效率提高8.3-23%。通过对转基因水稻愈伤组织的RNA-seq和RT-qPCR分析发现,rZmG2主要通过促进叶绿体发育相关基因的表达来提高水稻的分化效率。
rZmG2促进水稻再生。(A)载体pYLTAC380H-CSPpro::rZmG2,热激诱导可删除两个loxP之间的表达盒。(B~E) 分化阶段的水稻愈伤组织,B和C为籼稻品种,华占和华光,D和E为粳稻品种,DongJing和中嘉8号。
此外,利用团队前期开发的基于Cre/loxP的筛选标记剔除系统,通过对转化体幼苗进行热激处理,可实现rZmG2基因及其筛选标记基因表达盒的自删除(如下图2),以避免对植株生长发育造成影响,获得不带转基因筛选标记植株。该研究提供了一种高效的植物遗传转化新工具。

rZmG2转基因株系中标记删除检测。在热激诱导Cre酶基因表达条件下,pYLTAC380H-CSPpro::rZmG2
(图1A)转基因株系中两个loxP位点间的序列被完全删除。0.5-kb片段为PCR检测的删除片段。
华南农业大学硕士研究生罗婉妮和博士后谭健韬为该论文共同第一作者,郭晶心研究员和祝钦泷研究员为共同通讯作者。刘耀光院士参与了相关研究。该研究得到国家自然科学基金、广东省基础与应用研究重大专项、岭南现代农业项目实验室等资助。
图/文 生命科学院学院 郭晶心
